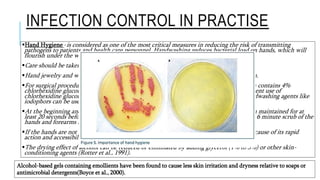
INFECTION CONTROL PROTOCOL DURING COVID-19 IN DENTISTRY

This document outlines infection control protocols for dental practices during the COVID-19 pandemic. It discusses personal protective equipment, patient handling protocols, waste management, instrument reprocessing, zoning within dental clinics, and guidelines from health organizations. Proper hand hygiene and the use of PPE like masks, gloves, and gowns are essential. High-risk aerosol-generating procedures require full PPE including N95 masks and face shields. Treatment areas must be disinfected after each patient. Non-emergency dental care may be postponed for patients suspected of having COVID-19.